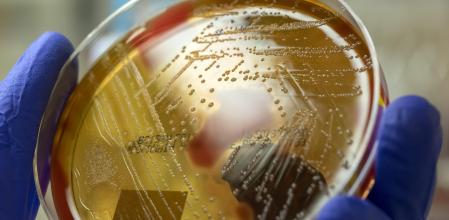
Cómo hacer frente a las superbacterias, una pandemia que causa miles de muertes

Hacer un mal uso o abusar de los antibióticos, tanto en el ámbito sanitario como en el veterinario, es una de las principales causas de una pandemia tan letal como silenciosa: las superbacterias. Según la Organización Mundial de la Salud (OMS), la gran capacidad de algunas bacterias para adaptarse y resistir a los medicamentos diseñados para combatirlas es ya una de las mayores amenazas para la salud pública mundial. Cada año mueren en el mundo 1,2 millones de personas por infecciones causadas por bacterias resistentes a los antibióticos y el futuro es poco esperanzador: en 2050, la cifra de fallecidos anuales podría alcanzar hasta los 10 millones en todo el mundo.
Ante tal panorama, los expertos urgen a tomar medidas para hacer frente a esta situación y revertir las nefastas proyecciones. Es por ello por lo que algunos países han empezado a reducir el consumo de antibióticos en entornos veterinarios y a racionalizar su uso sanitario para evitar nuevas superbacterias e intentar revocar las resistencias existentes. De hecho, hay bacterias que vuelven a hacerse sensibles cuando desaparece por un tiempo el antibiótico del entorno, advierten los especialistas. En cualquier caso, dar apoyo a la investigación resulta imprescindible para dar con avances como los que están logrando los científicos reunidos en el próximo Debate de CaixaResearch.
Cada año mueren en el mundo 1,2 millones de personas por infecciones causadas por bacterias resistentes a los antibióticos
Las bacterias resistentes a los antibióticos son especialmente preocupantes en los ámbitos clínicos ya que pueden afectar a personas ingresadas que estén bajas de defensas y convertir cirugías menores en un riesgo mortal, destacan desde el Consejo Superior de Investigaciones Científicas (CSIC). Si antes las bacterias multirresistentes atacaban a pacientes inmunodeprimidos en los hospitales o que estaban bajo tratamientos que reducen sus defensas, ahora estas ya han dado el salto a la comunidad dando por ejemplo lugar a tuberculosis e infecciones de transmisión sexual resistentes.
Los grandes retos de la investigación
Descubrir nuevos antibióticos eficaces contra estos microorganismos supone un desafío para la industria farmacéutica: la investigación puede durar décadas sin llegar a obtener resultados, lo que desincentiva la inversión de recursos. Los expertos proponen incorporar incentivos económicos para volver a potenciar su interés. Además, se están impulsando otras vías de investigación para encontrar nuevas herramientas terapéuticas. Tres científicos que están al frente de proyectos con apoyo de la Fundación ”la Caixa” y que buscan aportar soluciones a esta situación explicarán los retos a los que se enfrentan y cuáles están siendo sus últimos avances en un nuevo Debate de CaixaResearch. Este encuentro, que tendrá lugar el próximo 22 de mayo a las 19 horas, podrá seguirse online a través de caixaresearch.org tras inscribirse previamente.
La resistencia antimicrobiana, es decir, la capacidad que tienen las bacterias de adaptarse y hacerse resistentes a los medicamentos que usamos para combatirlas, se ha convertido en una de las mayores amenazas para la salud pública global
Los ponentes serán Daniel López Serrano, investigador principal en el grupo de Biología Molecular de las Infecciones en el Centro Nacional de Biotecnología (CNB) de Madrid; Javier Montenegro, investigador principal en el Centro Singular de Investigación en Química Biológica y Materiales Moleculares (CIQUS) y profesor titular de la Universidade de Santiago de Compostela, y Mireia López Siles, profesora, lectora e investigadora en el grupo de Microbiología de la Enfermedad Intestinal de la Universitat de Girona (UG).

El abuso de antibióticos genera superbacterias, desafiando la eficacia de los tratamientos y representando una amenaza para la salud pública, según la OMS
Los mayores desafíos de los investigadores
Tomar antibióticos cuando no es necesario para combatir una enfermedad o dejar un tratamiento de estos medicamentos a medias contribuye a crear bacterias resistentes. Además, la microbiota —la comunidad bacteriana natural de nuestro organismo que tiene un rol esencial en la salud intestinal y dermatológica, además de en nuestro sistema inmune, entre otros—, puede verse alterada por el consumo de estos fármacos. Otros factores que influyen en esta crisis sanitaria que crece de forma imparable son la ausencia de nuevas familias de antibióticos que refuercen el arsenal terapéutico y el aumento de los desplazamientos asociados a la globalización que ayudan a esparcir las resistencias por todo el mundo.
Reactivar la eficacia de algunos antibióticos
El proyecto liderado por Daniel López Serrano tiene por objeto recuperar la eficacia de los antibióticos que han dejado de funcionar debido al aumento de bacterias resistentes. En estudios previos su equipo descubrió un proceso celular esencial para la supervivencia de las bacterias durante las infecciones y ha podido diseñar tratamientos que inhiben este proceso. La gran ventaja de este enfoque es que se propone un tratamiento capaz de curar infecciones que no se podrían curar, y lo hace mediante la reactivación de antibióticos comercialmente disponibles.
Lograr atravesar la membrana de las bacterias
Cuando se desarrolla un nuevo antibiótico puede suceder que, aunque tenga una capacidad bactericida prometedora, no consiga atravesar la membrana de las bacterias. Las estrategias actuales para facilitar ese traspaso de la membrana no han conseguido ser totalmente eficaces. El proyecto encabezado por Javier Montenegro utiliza una nueva aproximación basada en la propiedad del boro para transportar los antibióticos al interior de las bacterias, además de tener mucho potencial para habilitar el uso de antibióticos ya existentes en cepas resistentes o de permeabilidad limitada.
Una nueva vacuna para prevenir infecciones
Klebsiella pneumoniae es una bacteria que se puede encontrar en cualquier ambiente, como en nuestra microbiota intestinal sin causar ningún daño. Sin embargo, en determinados contextos, puede provocar infecciones potencialmente mortales, siendo una importante causa de neumonías y septicemias en personas de todas las edades. La OMS ha clasificado esta bacteria entre las especies de preocupación crítica en el ámbito sanitario. El proyecto liderado por Mireia López Siles busca prevenir estas infecciones con la KlebsiGene, una vacuna de desarrollada por la Universitat de Girona y el Instituto de Salud Carlos III.

Imagen del debate CaixaResearch 'Superbacterias: ¿cómo podemos hacer frente a una de las mayores amenazas para la salud global?'